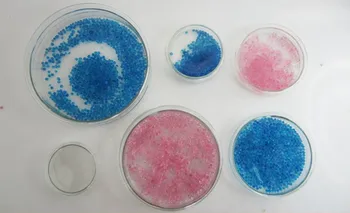

hair mesh wig cap hair nets wig liner hairnet snood glueless dome wig cap stretchable elastic hair net ty8611326, Black;brown

sku: 870051544
ACCORDING TO OUR RECORDS THIS PRODUCT IS NOT AVAILABLE NOW
353.35 руб.
Shipping from: China
Description
welcome to my store
Technical Details
Age Group: | adult |
Color: | Black;Brown |
gender: | unisex |
_GoogleCategoryID: | 7305 |
Price history chart & currency exchange rate
Customers also viewed

1,187.84 руб.
Winter Bow Girls Fashion Boots Design PU Cloth Patchwork Short Boots For Kids Plush Warm Anti Slip Zipper Children Ankle Boots
aliexpress.com
47.25 руб.
6/8mm 2m Fiberglass Rope Seal Black Stove Fire Rope Wood Burning Stove Log Burner Door Seal Stoves Accessories
aliexpress.com
6,155.93 руб.
Левый Правый верхний нижний передний бампер Нижняя решетка радиатора отделочные полосы 958505685109B9 958505877109B9 для Porsche Cayenne GTS 2011-2014
aliexpress.ru
3,535.02 руб.
Летнее модное дизайнерское платье Gedivoen с винтажным рисунком, женское свободное повседневное Праздничное Платье макси с рукавом летучая мышь
aliexpress.ru
3,850.31 руб.
Наружная накладка на ручку из углеродного волокна 16X для BMW 1 2 3 4 серии E87 E90 E91 E92 E93 F30 X1 X2 X3 X4 X5 X6 LHD
aliexpress.ru
7,025.23 руб.
Ботильоны женские и мужские на шнуровке, винтажные высокие ботинки на плоской толстой подошве, повседневные брендовые полусапожки, Rick
aliexpress.ru
1,370.34 руб.
Автомобильный беспроводной пульт дистанционного управления 12 в один буксир четыре в сети мигающие огни 24 светодиода высокомощные аварийные огни
aliexpress.ru
834.26 руб.
Автомобильный держатель для телефона Mercedes Benz A Class CLA W177 CLA W177 W118 C118 X156 W117, Гравитационный навигационный кронштейн, вращающийся держатель
aliexpress.ru
770.71 руб.
Сменная головка SH50 для бритвы Philips S5420 S5000 S5370 S5140 S5110 S5050 S5210 S5230 S5270 S5271 S5340
aliexpress.ru
177.61 руб.
Инструмент для ремонта автомобильных фар HGKJ, универсальный очиститель окон, портативный инструмент для ремонта автомобильных фар
aliexpress.ru
487.20 руб.
Маленькая модель, Женский студенческий винтажный армейский зеленый лес, маленький свежий стиль Академии
aliexpress.ru
421.20 руб.
Многофункциональная дизайнерская сетчатая очень большая сумка для хранения баскетбола на шнурке для спортзала, футбольной сумки, сумка для хранения баскетбола
aliexpress.ru
43.99 руб.
High Temperature Tape Brown Insulation Tape round High Temperature Pi Polyimide
aliexpress.ru
508.38 руб.
Cute Lace Pet Clothes for Cats and Dogs, Tutu Print Skirt, A-line Skirt, Small and Medium-Sized Dog Dress, Spring and Summer
aliexpress.ru
78.21 руб.
10PCS 2.54mm XH2.54 Female Connector Terminal Cable 10cm 20cm 30cm 2p 3p 4p 5p 6p 7p 8p 9p 10p 11p12p Single/Double Head Wire
aliexpress.ru
928.77 руб.
Men Sports Long Sleeve Fitness Cloth Elastic Bodysuit Running Compression Shirt Long Sleeve
aliexpress.ru
1,572.39 руб.
LJL-2-Pack V-Type, блок шкива из нержавеющей стали, беззвучные подшипники, канавка, скользящее роликовое гусеничное колесо
aliexpress.ru215.30 руб.
(1 Pcs) Map Harmonika Expanding File Handle Tenteng JOYKO EF-2638 Plastik Button Dokumen Sertifikat Berkas Folio F4 FC Nota Giro
shopee.co.id675.49 руб.
Promo Piring Makan Keramik Hermes Satuan / Piring Ceper Keramik Hermes - Saucers 6 Berkualitas
shopee.co.id
2,836.81 руб.
skirts summer women's linen pleated maxi long beach boho vintage casual skirt y95n#, Black
dhgate.com
1,116.39 руб.
Длинное платье в горошек, тренд этой весны лето, 00578 (Оливковый), Размер 48 (XL)
prom.ua
1,357.30 руб.
18pcs 3d gingerbread house stainless steel christmas scenario cookie cutters set biscuit mold fondant cutter baking tool moulds
dhgate.com
1,641.64 руб.
2020 team pro cycling jersey 20D pads bike shorts set Ropa Ciclismo mens quick dry bike Maillot Culotte clothing suit
aliexpress.com
933.66 руб.
Hair Dressing Hair Dyeing Shawl Aprons Waterproof Non-stick Neck Cape Wrap Hair Cutting Collar for Salon (White)
aliexpress.com
1,888.49 руб.
petri dish 90mm ,educational equipment ,laboratory glassware student home lab equipment
aliexpress.com
2,117.43 руб.
Lens Aperture Group Flex Cable For Canon EF-S 15-85 mm 15-85mm f/3.5-5.6 IS USM Repair Part
aliexpress.com
2,575.29 руб.
For PGYTECH DJI Osmo Pocket Foldable Phone Holder Plus Bracket for DJI Osmo Pocket Accessories
aliexpress.com
3,258.83 руб.
EC.J2701.001 HIGI QUALITY PROJECTOR LAMP/BULB FOR ACER PD523PD/PD525PW/PD527D/PD527W
aliexpress.com
1,433.07 руб.
For MSI Gx660R GT660 Hard Drive HDD SATA Connector Adapter Board MS-16F1C Full Tested Free Shipping
aliexpress.com
128.72 руб.
Japanese Colorful Stripes and Dots Washi Tape Paper Adhesive Tape Masking Tape DIY Decorative Scrapbooking Diary Sticker Label
aliexpress.com
29,858.23 руб.
dhl or fedex 10pcs 4K HDMI Splitter 1X8 port distributes 1 HDMI source to 8 HDMI displays simultaneously 3D Amplifier
aliexpress.com